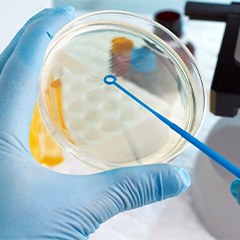
microbiology training in chennai

Veridian provides advanced microbiology training in Chennai designed for students, researchers, and professionals seeking hands-on laboratory experience. This microbiology training program combines theory and practical sessions to teach participants key methods such as microbial culture, staining, isolation, and identification. Trainees also receive familiarity with sterilisation methods, antibiotic sensitivity testing, and biosafety procedures used in clinical and industrial labs.
Under the direction of knowledgeable instructors, this microbiology training in Chennai highlights practical applications and safe lab management, giving students the self-assurance and technical skills necessary for contemporary biotechnology and research fields. Whether you want to grow academically or work in diagnostics or pharmaceuticals, Veridian's microbiology training program will provide you with the practical knowledge and professional expertise.



Veridian's Microbiology Training Program is intended to give professionals, researchers, and students a thorough understanding of microorganisms and their useful applications in industry, research, and healthcare. The goal of this practical microbiology training is to build strong conceptual knowledge and practical laboratory skills.


Participants will gain knowledge of fundamental microbiological procedures like microbial culture, staining, isolation, and biochemical testing through organised sessions. For microbiology students who want to obtain hands-on training in microbiology, the course is perfect because it covers advanced subjects like environmental and industrial microbiology, antibiotic resistance, and biosafety procedures.
This microbiology training program connects classroom instruction with practical applications utilised in research and diagnostic labs, under the direction of knowledgeable faculty and lab specialists. Additionally, students will learn about clinical and industrial procedures related to biotechnology, food safety, and pharmaceuticals.


With scientific expertise, analytical abilities, and a recognised certification, Veridian's advanced microbiology training in Chennai gives students a solid basis for employment in the biotech, pharmaceutical, environmental, and diagnostics sectors.
Gain knowledge from skilled microbiologists and business experts who have worked in clinical, industrial, and research microbiology for a long time.
Participate in live lab sessions covering microbial culture, staining, isolation, and biochemical testing methods to obtain hands-on experience.
Receive dedicated support in building a professional resume, refining your LinkedIn profile, and preparing for job interviews.


Research collaborations, training programs, industrial services, and consultations in biotechnology and life sciences.